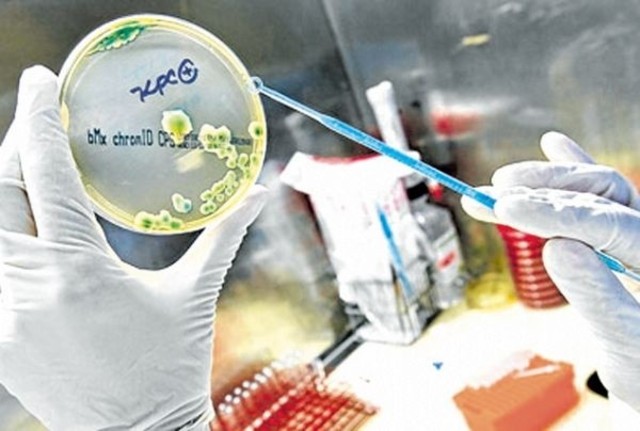
Detectan bacteria resistente y hay un muerto en Maldonado

-
-
En los meses de más calor, que son los primeros del año, hay sectores como el turismo que viven su mejor zafra. Pero las altas temperaturas también significan pérdidas millonarias para otro: la actividad agropecuaria.
Millones de dólares en pérdidas por la falta de agua -
En un año en que las noticias policiales centraron el interés de la gente en el caso de “El Pelón” -un menor que tras matar a dos personas estaba libre y volvió a matar- ejemplifica la situación por la que atraviesa el país.
Menor cometió tres homicidios en siete meses: polémica por liberación -
Fueron necesarios 51 años de guerra y 829 víctimas para que la organización terrorista vasca, severamente golpeada en los últimos años por operativos policiales españoles y franceses, decidiera en enero anunciar un alto el fuego “permanente, general y verificable”.
Tras cinco décadas, ETA perdió la guerra -
En el mes de febrero la Justicia condenó a nueve años de prisión al homicida de la joven, uno de los casos policiales más resonados de los últimos años. Luego de tres años de investigaciones, el juez penal de Maldonado, Gabriel Ohanian, determinó la condena para el joven, por un delito de homicidio.
Tres años de la muerte de Natalia Martínez, cayó el matador -
A fines de 2010 un joven verdulero tunecino comenzó, sin saberlo, una gran revolución que sacudió a los países del norte de África y de Oriente Próximo.La primavera que sacudió a un continente
-
Jorge Drexler sumó en febrero de este año otro lauro a su exitosa carrera internacional: recibió el Premio Goya a la mejor canción original que creó para la película “Lope”.Drexler y un Premio Goya a la mejor canción original
-
Los premio Oscar 2011 no arrojaron ninguna sorpresa. Las películas favoritas se llevaron los galardones de la industria del cine estadounidense.
Un Oscar sin sopresas -
Wikileaks fue el principal protagonista de la mayo filtración de cables secretos de la historia. De Uruguay también trascendieron algunos secretos bien guardados.
Lea "Los secretos filtrados que salpicaron desde EE.UU. a Uruguay" -
La aparición de un video en el que presuntos militares amenazaban a integrantes del Poder Judicial sacudió la agenda noticiosa de marzo.
Lea "Amenaza de supuestos militares que terminó en el olvido" -
Bastaron seis minutos para que la tierra temblara. El 11 de marzo un terremoto de 9,0 grados provocó una de las peores catástrofes de la historia de Japón.Japón estima un elevado número de víctimas a causa del terremoto
-
Varios cables de agencia se han referido a ella como “estadounidense”, por lo que conviene recordar que Dame Elizabeth Rosemond Taylor nació en Londres un 27 de febrero de 1932 y falleció el 23 de marzo en un hospital de Los Angeles donde estaba siendo tratada por una insuficiencia cardíaca desde seis semanas antes.
Lea "Adiós a la última leyenda de Hollywood" -
La crisis financiera europea volvió a recrudecer a partir de abril. La situación derrumbó varios gobiernos y puso en entredicho la propia existencia de la moneda única, el euro.Europa en crisis y el euro bajo un manto de dudas
-
Doce niñas fueron asesinadas por un joven carioca en las aulas de su vieja escuela.
Masacre en colegio de Río de Janeiro -
En su informe sobre derechos humanos 2010 presentado en el mes de abril, el Departamento de Estado de Estados Unidos calificó de "inhumana" la situación en las cárceles en Uruguay, aunque destacó avances del gobierno en el tema. EE.UU. calificó de inhumana la situación en las cárceles uruguayas
-
A principios del mes de abril, el Frente Amplio (FA) entraba en la recta final para definir un tema por demás urticante: la anulación de la Ley de Caducidad.Quiebre en la bancada del Frente Amplio
-
En el mes de abril, el Ministerio de Salud Pública detectó en pacientes del interior del país internados en Centros de Terapia Intensiva una bacteria multirresistente a antibióticos, conocida como KPC.Detectan bacteria resistente y hay un muerto en Maldonado
-
El príncipe Guillermo y Kate Middleton contrajeron matrimonio el 29 de abril en la Abadía de Westminster de Londres en una ceremonia fastuosa seguida en todo el planeta por miles de millones de televidentes.Inglaterra tiene nueva princesaInglaterra tiene nueva princesa
-
Las Torres Gemelas no habían terminado de caer y el mundo ya sabía que el responsable iba a pagar muy caro lo que acababa de hacer.El día que EE.UU. se vengó de Bin Laden
-
El 1° de mayo, el Papa Benedicto XVI beatificó a su antecesor, Juan Pablo II, ante un millón y medio de personas que llenaron la Plaza de San Pedro y las calles aledañas.Juan Pablo II rumbo a la canonización
-
La Justicia estadounidense terminó archivando la denuncia contra Dominique Strauss-Kahn, acusado por una camarera guineana de haber intentado violarla en un hotel de Nueva York. Un “affaire” sexual derrumbó al uno del FMI
-
El movimiento que nació de manera espontánea en Madrid se extendió por más de 50 ciudades españolas y sus reclamos fueron reproducidos en 900 ciudades de 82 países. Los “indignados” nacieron en España y se expandieron por el mundo
-
No pudo la presión del Frente Amplio y las amenazas de quitarle su banca. Tampoco un pedido público del presidente José Mujica. El diputado oficialista Víctor Semproni se mantuvo firme en su posición y, con su retiro de sala, el FA no pudo aprobar la anulación de la Ley de Caducidad.Diputado rebelde permitió mantener Ley de Caducidad
-
El 74% opinó que la “forma de actuar” de Mujica en relación a este tema era “mala” o “muy mala”.Uruguay al tope de la percepción de inseguridad
-
El espectáculo uruguayo se vistió de gala para celebrar una nueva edición de los Premios Iris. En una jornada en la que no faltó nada y con un gran despliegue en la producción, El País premió a las figuras del medio local.Premios Iris: Nacho Álvarez fue de Oro
-
El cáncer que padece Hugo Chávez cambió su aspecto: lo hizo engordar y perdió el pelo por los tratamientos a los que fue sometido en Cuba. Sin embargo, en ningún momento dejó el poder y no hubo cambios en la línea política de Venezuela.El cáncer cambió el físico de Chávez, pero no su gobierno
-
Un inusual fenómeno sorprendió a los uruguayos y generó incertidumbre entre quienes esperaban la partida o el arribo de alguno de los 584 vuelos que, hasta mediados de diciembre, fueron cancelados. Cenizas volcánicas en territorio nacional
-
La modelo argentina Zaira Nara anunció en su cuenta Twitter el 12 de junio que su relación con el uruguayo Diego Forlán, había llegado a su fin, a pocas semanas de la fecha fijada para una boda de ensueño.La ruptura mediática de la pareja del momentoLa ruptura mediática de la pareja del momento
-
El príncipe Alberto II de Mónaco, heredero de una dinastía que reina desde hace más de 700 años, y la excampeona de natación sudafricana Charlene Wittstock contrajeron el 1º de julio matrimonio por lo civil y al día siguiente en una ceremonia religiosa. Mónaco de fiesta; se concretó el enlace real
-
El presidente se vio obligado a remover a la ministra de Desarrollo Social y el entonces titular de Defensa presentó su renuncia.Primera crisis ministerial de la gestión Mujica
-
El domingo 18 de julio, a los 83 años, falleció el exdictador uruguayo Juan María Bordaberry y con su muerte se cerró uno de los capítulos más polémicos de la historia política del país. Muerte de Bordaberry cerró una etapa de la política uruguaya
-
Tres homicidios cometidos en dos rapiñas perpetradas a comercios en el mismo día provocaron una multitudinaria movilización en reclamo de mayor seguridad.Paro masivo de comerciantes ante ola de rapiñas fatales
-
El 2011 fue uno de esos años lindos para mirar atrás y repasar lo vivido, pero si hay un mes que se destaca ese es sin dudas julio, con la Copa América disputada en Argentina.La Celeste conquistó la 15
-
Por primera vez en 2011 el billete verde registró un incremento mensual, impulsado por las compras estatales, en un contexto de muy fuerte inestabilidad de los principales mercados financieros internacionales.Dólar registró en julio el primer aumento mensual de 2011
-
Días después de una múltiple interpelación a tres ministros de José Mujica por la instalación de la minera Aratirí, la empresa decidió enfriar su proyecto.Marcha atrás del gigante minero
-
La muerte de joven de 29 años, padre de cuatro hijos, ultimado durante un operativo policial en un barrio periférico de Londres, derivó en los peores disturbios que la ciudad vio en los últimos 20 años. Heridos, incendios y saqueos en Londres
-
El 13 de agosto Alemania recordó, en emocionante ceremonia, los 50 años de la construcción del Muro de Berlín por la dictadura comunista de Alemania Oriental.50 años del muro que dividió al mundo
-
El 23 de agosto pasado el presidente José Mujica envió al Parlamento el proyecto que crea un impuesto a la tierra .Un proyecto polémico: el impuesto a la tierra
-
A tres meses de iniciadas las revueltas estudiantiles, un joven de 14 años perdió la vida al recibir un disparo en medio de un enfrentamiento entre manifestantes y la Policía.Murió un joven chileno en protestas estudiantiles
-
Estados Unidos antes y después de IreneEl huracán que azotó al país en agosto tuvo como saldo 32 muertes, pérdidas millonarias y estado de alerta en varias regiones.
-
El miércoles 31 de agosto la Suprema Corte de Justicia (SCJ) liberó por gracia al exbanquero Juan Peirano Basso, en prisión desde 2008 en Uruguay —pero detenido en 2006 en Estados Unidos— por el delito de insolvencia societaria fraudulenta.Tras cinco años de prisión, Juan Peirano Basso recuperó la libertad
-
El 18 de setiembre la Justicia Militar dispuso el procesamiento con prisión de cinco marinos uruguayos que estuvieron involucrados en el abuso a un joven en Haití.
Cinco Marinos fueron a prisión por abusos a un civil haitiano -
La mañana del 11 de setiembre del 2001 todo parecía normal en el Bajo Manhattan. En las torres del World Trade Center, imagen icónica de Nueva York se preparaban para desarrollar una jornada de trabajo con normalidad. A diez años de la globalización del terrorismo
-
El cerrojo de un rancho quebrado con una uña de metal por un funcionario de la Intendencia de Rocha, ante las protestas e insultos de decenas de personas, fue la primera postal que dejó la iniciativa de la Intendencia de Rocha. Derrumban 70 viviendas en Punta del Diablo
-
Pocas muertes este año causaron tanto impacto como la de Steve Jobs. Luego de un larga lucha contra un cáncer de páncreas, en la noche 5 de de octubre, el cofundador de Apple falleció.El mundo perdió a uno de sus genios contemporáneos
-
En el mes de octubre, el expresidente Tabaré Vázquez sorprendió a propios y extraños al declarar que pidió el apoyo de Estados Unidos durante el diferendo con Argentia por la instalación de Botnia.Vázquez renuncia después de una revelación polémica
-
El 2011 fue un año crítico para la salud pública. El conflicto entre funcionarios y gobierno derivó en huelgas y paros que afectaron severamente la atención en CTI, emergencias y otras dependencias de varios nosocomios.Una muerte marcó el peor momento de la crisis en salud pública
-
Después de varios meses de revueltas en el mundo árabe, la muerte del líder libio Muamar Gadafi marcó un antes y un después para la vida social y política de aquel país.Un desenlace esperado: murió Gadafi
-
El Frente Amplio aprobó en el Senado y luego en Diputados (solo con votos oficialistas) el proyecto de ley que declaró que los delitos cometidos durante la dictadura son de lesa humanidad, con lo que se eliminó la proscripción de los mismos.Solo con votos del FA, se aprobó suspender prescripción de delitos de la dictadura
-
En el 2011 se alcanzó una marca histórica. La humanidad llegó a 7.000 millones de habitantes en el planeta. Se alcanzaron los 7 mil millones de pobladores
-
El 2 de noviembre, el juez del crimen organizado Jorge Díaz le tipificó seis delitos de peculado en reiteración real y un delito de estafa a la magistrada Anabella Damasco quien, entre 2004 y 2007, retiró dinero incautado en casos a su cargo.Procesan con prisión a la jueza Anabella Damasco por peculado
-
La noticia cayó como una bomba en los primeros días de Noviembre. Nicolás Sarkozy arremetía contra Uruguay al incluirlo en la lista de paraísos fiscales.Para Sarkozy Uruguay es un paraíso fiscal
-
-
“Educación, educación, educación. Y otra vez, educación”, dijo José Mujica el 1° de marzo de 2010 en su juramento ante la Asamblea General.La educación en constante debate
-
La jueza penal Fanny Canessa desestimó procesar a Arana, Muñoz y Rosselli, concluyendo que los mismos fueron engañados por Bengoa.Arana, Muñoz y Rosselli absueltos por el caso Casinos
-
El maestro y periodista Julio Castro fue ejecutado con un disparo en el cráneo. Luego de más de 30 años desde su desaparición, sus restos fueron hallados en un predio del Ejército, en el batallón 14 en Toledo.Aparecieron los restos de Julio Castro
-
El 1° de setiembre comenzó el Censo 2011; el anterior se había realizado en 1996. Ya finalizando el año, aún no ha terminado.El Censo sin fin
-
Fue necesaria una incalculable cantidad de agua, un operativo que durante siete días involucró a centenares de personas y una ayuda del clima para que se extinguiera, en el departamento de Rocha, el primer gran incendio forestal de la temporada.Llevó una semana extinguir el primer gran incendio forestal del verano
-
En setiembre, la Presidencia anunció con toda pomposidad que se había logrado un acuerdo entre los 19 intendentes para poner fin a más de 40 años de “guerra de patentes” .Tras cuatro décadas la guerra de las patentes parece llegar a su fin
Plan projects on a visual timeline
Map milestones, phases, deadlines, and key events in one place so the sequence is easier to see and share. Timetoast is a timeline maker for work, school, research, and stories.